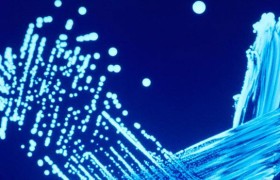
Nuevo alcance de ENAC

Monthly Archives: diciembre 2013
Interpretación de los análisis de suelos
…
Continue reading →Nuevo alcance de ENAC
En días pasados hemos renovado y ampliado nuestro alcance de la Acreditación de ENAC, teniendo ahora acreditados la Detección y Recuento de Legionella spp según la UNE-EN ISO 11731:2007 en aguas de consumo y aguas continentales tratadas no destinadas al consumo humano, el recuento de enterococos en aguas de consumo…
Continue reading →Millones de personas en el mundo carecen de agua potable
Acabo de leer un artículo muy interesante en water.org sobre la falta de acceso al agua en el mundo y me hace reflexionar sobre lo poco que se valora en muchas ocasiones el tratamiento adecuado del agua en España y llevar los controles de análisis adecuados. En muchas ocasiones oigo decir a…
Continue reading →